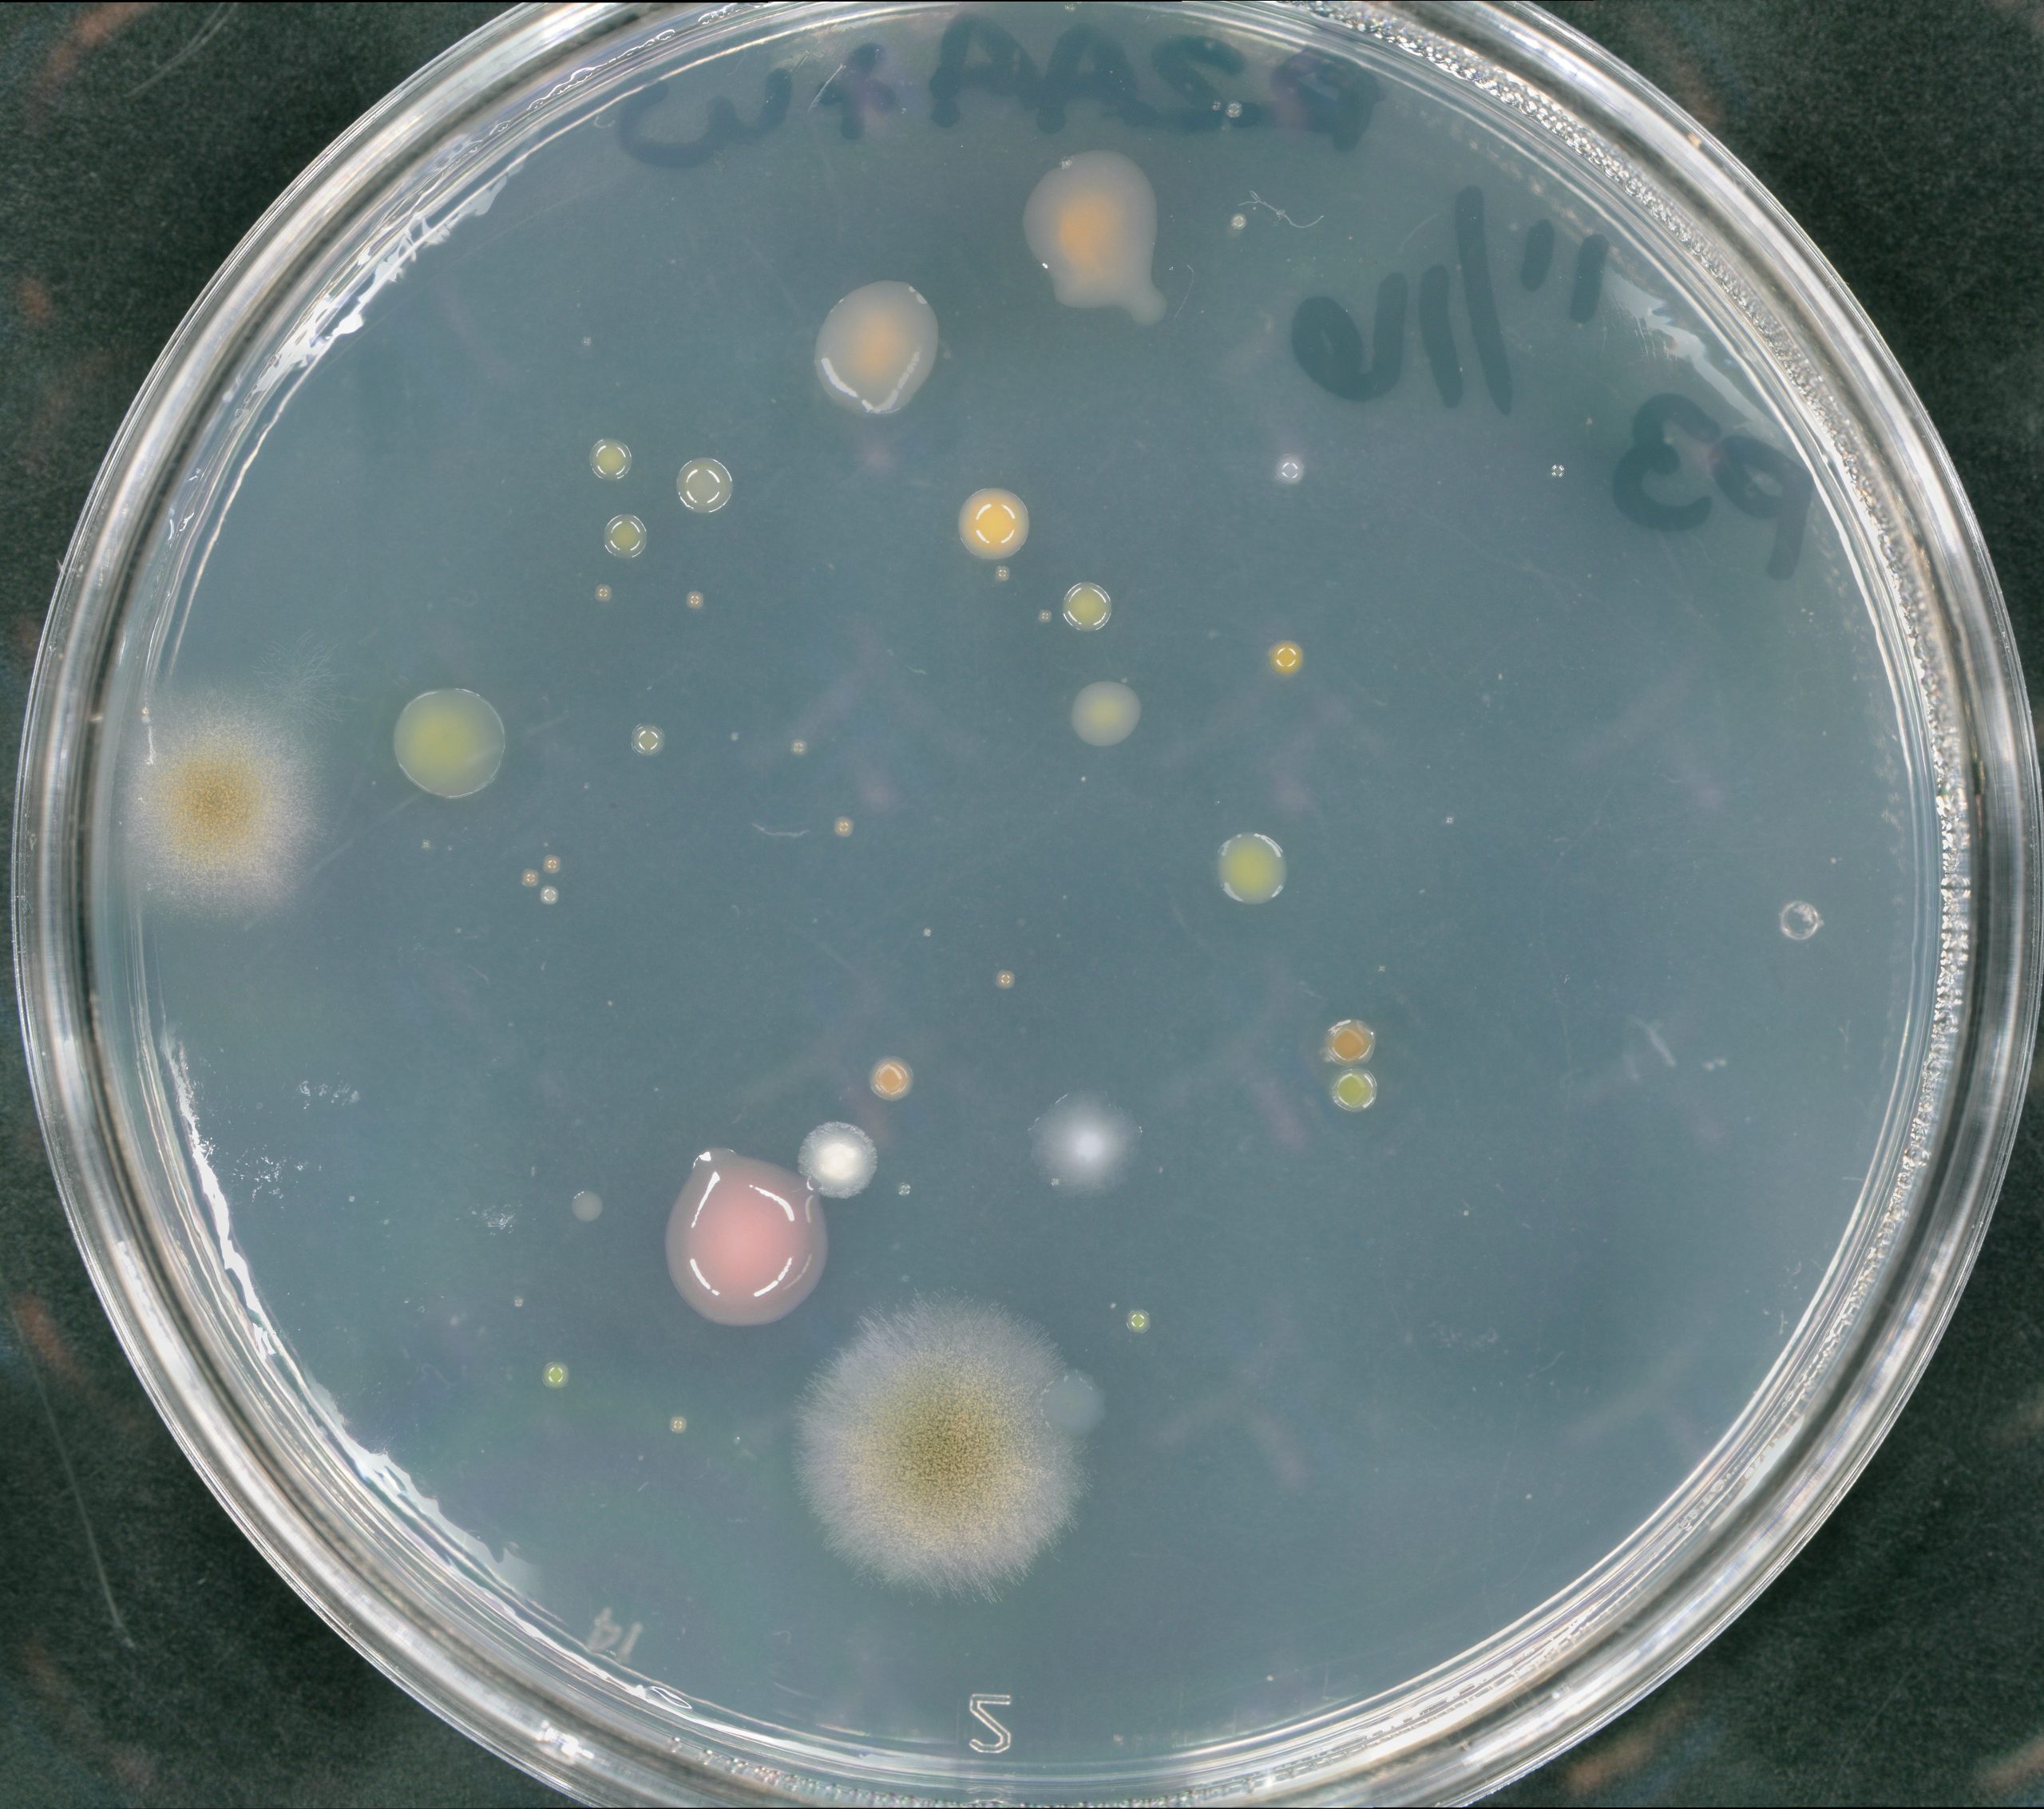

How do organisms get their shapes?
Our lab is interested in understanding the mechanisms and mechanics of morphogenesis in brown macroalgae and plants.
While these two groups of eukaryotes evolved separately, they have strikingly similar features central to our research: complex developmental patterning mechanisms, functionally analogous organs, & polysaccharide-based cell walls.
Current Research Themes in Our Lab
Cell expansion, cell shape, and morphology in plants. The control of plant cell expansion on cell, tissue, and organ levels is a key process in growth and development, with impacts on organismal form & function. We examine such processes by centering the mechanical role of the cell wall in regulating cell expansion and shape; our major study system in the Arabidopsis hypocotyl. What components of the cell wall permit and restrict growth? What organ and tissue-level hormonal controls regulate cell expansion, via the wall? How do changes in the execution of cell expansion and cell shape impact organismal function? Find out more here!
Morphology, Growth, & Development in Brown Macroalgae. We are curious about brown macroalgae here in California, focusing on the orders Fucales and Laminarales (kelp). Our lab is currently interested in three major areas: branching patterns/phyllotxais, embryo development, and environmental impacts on growth. Learn more about current projects here!
|
|
|
|
The brown algal cell wall and its role in growth, development, and survival. The cell wall plays a mechanical role in regulating organismal growth and it is the organism’s major interface with the external biotic and abiotic environment. The same polysaccharides in the wall important for growth & development also play roles in the algal microbiome and even heavy metal tolerance. Check out our current projects here!
|
|
|
Methods & tool development for brown macroalgae. Brown macroalgae are tough, and they don’t make molecular biology easy – but we think they are worth careful, patient, persistent effort. Together with a small-but-mighty research community we are optimizing, adapting, and developing methods and tools needed for modern molecular biology in brown algae. Examples in our lab include: quality, purpose-driven, nucleic acid extraction methods; advanced imaging methods with confocal & AFM; RNAseq for de novo transcriptome assembly & gene expression analyses; laser capture microdissection; and RNAi and CRISPR-gene editing.
Want to know more about cell walls? Check out the iBiology video below! Go to iBiology to see more on plant and algal cell walls!
![]() Please note that all images are Creative Commons CC-BY
Please note that all images are Creative Commons CC-BY
Our Lab, at UCLA, acknowledges the Gabrielino/Tongva peoples as the traditional land caretakers of Tovaangar (the Los Angeles basin and So. Channel Islands). As a land grant institution, we pay our respects to the Honuukvetam (Ancestors), ‘Ahiihirom (Elders) and ‘Eyoohiinkem (our relatives/relations) past, present and emerging. Learn more about UCLA’s work here. Learn more about the Gabrielino/Tongva peoples here.